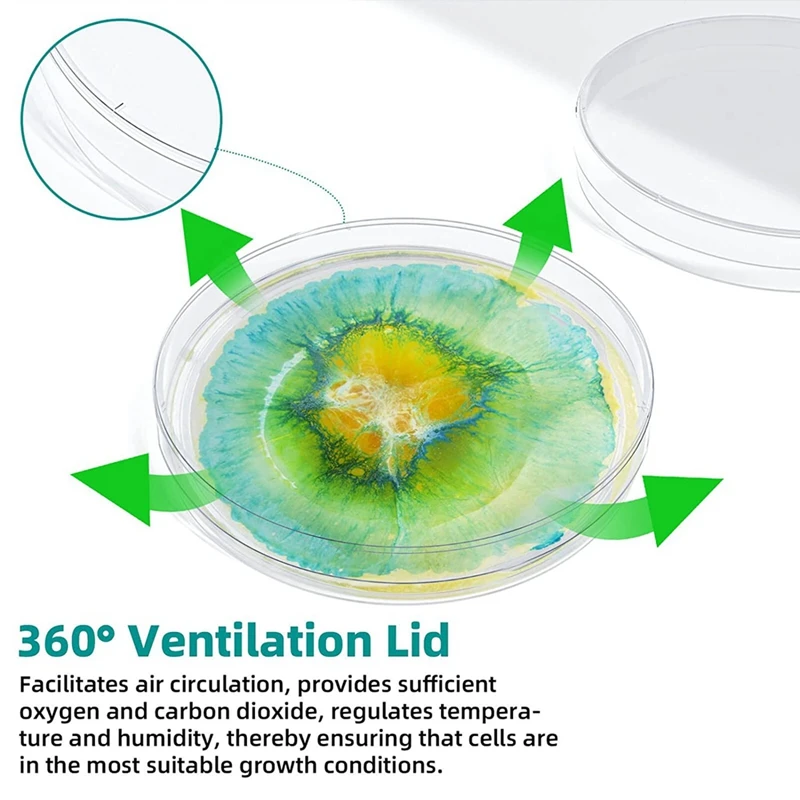

Стерильная пластиковая глубоко прозрачная тарелка для лабораторного анализа, школьных проектов, образцов крови, бактерий, посева клеток семян
Price history chart & currency exchange rate
Customers also viewed

$2.58
DIY Cute Quiet Book Educational Kuromi Homemade Book Colourful Melody Quiet Book Decompression Toy book Children Handmade Toy
aliexpress.com
$38.90
1# 5,000pcs! Pink translucent-Clear colored empty capsule,hard gelatin empty capsule!(joined or seperated capsules available!)
aliexpress.com
$29.80
Suitable for excavator common rail fuel pressure sensor auto parts 344-7390 7PP4-2
aliexpress.com
$1,237.00
New crystal chandelier Luxury Island Fixture for living room Dining room light Modern villa shaped art chandelier
aliexpress.com
$87.85
Радиатор RETROstyle Derby CH 500/070 x3, Бордовый;бронзовый;зеленый;золотой;коричневый;медный;серый;синий;черный, Derby CH 500/070 x3
dkrussia.com$4.30
KOPI KAPSUL CITIAMO SOLID VARIAN PRIME COFFEE 100% ARABICA COFFEE CAPSULE MESIN KOPI FORTE
shopee.co.id
$20.96
Chapeau Kentucky Derby Fascinateurs Casque Plume Lin / Viscose Mariage Course de chevaux La Saint-Patrick Journée des dames Coupe de Melbourne Rétro Vintage Elégant & Luxueux Avec Plume Fleur Casque
lightinthebox.com
$28.37
Men Plaid Shirt Streetwear Hip Hop Patchwork Button Up Long Sleeve Cotton Shirt 2022 Autumn Harajuku Vintage Casual Loose Shirts
aliexpress.com
$27.56
Мужская теплая флисовая Военная тактическая куртка на осень и зиму, Уличный спорт, походный кемпинг, мягкий пуловер с ракушкой, тренировочн...
aliexpress.com
$12.50
Autumn Long Sleeve Women Shirt Office Lady Bow Woman Shirt Corduroy Plus Thick Solid Color Women Blouses Turn-Down Collar Top
joybuy.com

![adidas [S Market] кроссовки adidas EQUIPMENTS 10 U IF0186
adidas [S Market] кроссовки adidas EQUIPMENTS 10 U IF0186](http://img.joomcdn.net/c8da445e9fd3cbd299776654d4e328a76a0a6f2f_original.jpeg)







